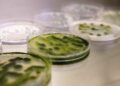
Microalga de Huelva capaz de bajar los triglicéridos y el colesterol

El innovador proceso de selección que la Diputación Foral de Bizkaia puso en marcha hace más de dos años para celebrar una Oferta Pública de Empleo (OPE) específica para personas con discapacidad intelectual ha sido galardonado en Toledo.
El trabajo de la Institución foral desarrollado para la consecución con éxito de esta OPE ha sido reconocido en los primeros ‘Premios de Empleo Público y Discapacidad Intelectual’. Dicho premio lo otorga la entidad Plena Inclusión, en concreto, en la categoría ‘colaboración con el Tercer Sector’.
Junto a Bizkaia, han sido también galardonadas la Junta de Castilla y León, la Junta de Andalucía, en las categorías ‘Apoyos en el puesto de trabajo’ y ‘Trayectoria’, respectivamente. A esta primera edición de estos galardones se habían presentado 16 candidaturas de administraciones públicas del Estado, según ha informado la institución foral.
La entidad Plena Inclusión distingue con estos premios la labor de administraciones públicas que han desarrollado convocatorias específicas de empleo público para personas con discapacidad intelectual, como es el caso de la Diputación Foral de Bizkaia. La ceremonia se ha desarrollado en el marco de un seminario técnico al que han asistido 150 personas.
Un proceso AD Hoc e innovador
La Diputación Foral de Bizkaia convocó en noviembre de 2017 una oposición destinada a cubrir cinco plazas de la categoría de personal de servicios-puesto de subalterno dirigida en exclusiva a personas con discapacidad intelectual, con un grado reconocido igual o superior al 33%.
En la misma se inscribieron 216 aspirantes que tuvieron que superar un proceso selectivo innovador y ad hoc. Para llevarlo a cabo, la Institución foral elaboró toda una serie de materiales y textos específicos adaptados a un proceso selectivo de estas características. Un proceso en el que en todo momento ha estado asesorada por las organizaciones del tercer sector que trabajan con este colectivo de personas.
Estas entidades (APNABI-Autismo Bizkaia, Gaude, Fundación Síndrome de Down del País Vasco y Lantegi Batuak) han seguido colaborando, acompañando y ayudando a estas personas a adaptarse a sus nuevos puestos de trabajo.
La Institución foral se convirtió en 2017 en la primera Administración vasca que convocó plazas dirigidas específicamente a personas de este colectivo. Este año seguirá avanzando en la inclusión real y efectiva de las personas con discapacidad intelectual con una nueva convocatoria que se concretará en los próximos meses.